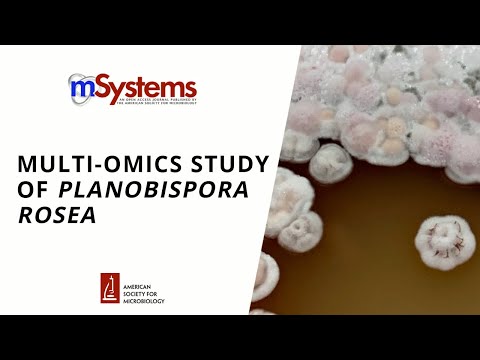
YouTube video

TOPCAPI Project retweetledi

Researchers @UoMMIB in the UK and @umncbs in the US have teamed up to understand how the microbes found in #soil interact with one another and with #plants, and whether this knowledge could be harnessed to bring benefits to #agriculture.
futurumcareers.com/what-lies-bene…
English